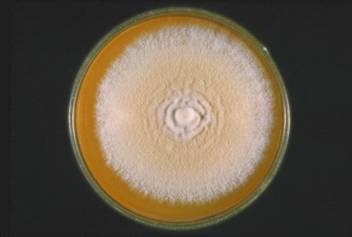

Трихофития у щенков
ОГЛАВЛЕНИЕ
Введение
Глава
1. Стригущий лишай (трихофития) у собак
.1 Определение
болезни. Эпизоотические данные. Характеристика возбудителей трихофитии у собак
1.2 Патогенез.
Клинические признаки трихофитии у собак
Глава
2. Диагностика. Лечение. Профилактика и меры борьбы трихофитии у собак
Глава
3. История болезни щенка с диагнозом трихофития
Заключение
Список
литературы
ВВЕДЕНИЕ
Актуальность
работы. Перед отечественной ветеринарией и микологией
остро стоит вопрос о совершенствовании существующих и разработке новых методов
диагностики дерматомикозов, а также индикации возбудителей микозов в объектах
внешней среды. Изменение экологического фона в ряде республик и областей,
процессы урбанизации и связанные с ними изменения структуры и границ нозоареалов
этих заболеваний, вносят серьезные изменения в эпидемиологию и влияют на
характер клинического течения современных зоонозных дерматомикозов у животных и
их владельцев. Это способствует распространению зоонозных дерматомикозов в
различающихся по климатогеографическим, экономическим и экологическим условиям
ареалах страны [15].
Изучению проблем трихофитии, обусловленной
зоофильнымн трихофитонами, посвящены исследования Н.А. Медведевой (1968), П.Н.
Пестерева (1988), Э.В Чистяковой (1992). В них освещены особенности морфологии
грибов-возбудителей, вопросы эпидемиологи, патогенеза, клиники и лечения данных
микозов. Однако за последнее десятилетие изменились спектр возбудителей и
клинические проявления трихофитии, что указывает на необходимость дальнейшего
изучения этнологического своеобразия и клинических особенностей последней.
Проблеме патогенеза трихофитии, в том числе и изучению процессов иммуногенез
при данном микозе, посвящены исследования Ю.А. Медведева (1989) и других
авторов [8].
Характерной особенностью всех
дерматомикозов и трихофитии у собак, в частности, является видоизменение
микробиоты. Если раньше наиболее частыми возбудителями дерматомикозов были
антропофильные грибы, то сейчас на их долю приходится не более 1% микобиоты.
Основными возбудителями микроспории и трихофитии стали зоофильные грибы. Для
трихофитии - это Trichophyton
verrucosum и T. mentagrophytes
var. gypseum
[5].
Цель работы: изучить
особенности трихофитии у собак, составить историю болезни щенка с диагнозом
трихофития.
Предмет работы: трихофития.
Объект работы: щенок
с диагнозом трихофития.
Задачи работы:
1. Дать понятие трихофитии, эпизоотические
данные, характеристику возбудителей трихофитии у собак.
. Рассмотреть патогенез и клинические признаки
трихофитии у собак.
. Изучить методы диагностики, лечение и
профилактику трихофитии у собак.
. Составить историю болезни курируемого щенка с
диагнозом трихофития.
Методы исследования: анализ
литературы по данной теме, синтез, абстрагирование, обобщение, наблюдение,
медицинское исследование.
Объем и структура работы. Курсовая
работа изложена на 37 страницах печатного текста. Курсовая состоит из введения,
трех глав, включающих параграфы, заключения и списка использованной литературы.
Список литературы включает 40 источников, из них 34 отечественных и 6
зарубежных авторов.
ГЛАВА 1. СТРИГУЩИЙ ЛИШАЙ
(ТРИХОФИТИЯ) У СОБАК
.1 Определение болезни.
Эпизоотические данные. Характеристика возбудителей трихофитии у собак
Трихофития - распространенное
среди дерматомикозов собак заболевание, основными возбудителями которой
являются Trichophyton
verrucosum и Trichophyton
mentagrophytes
var. gypseum.
Трихофития - природно-очаговая инфекция, эпидемические особенности и
периодичность вспышек которой зависят от географических, экологических и ряда
других факторов [11].
Источником инфекции является
больной человек, животные или почва. Возбудители устойчивы к действию
окружающей среды, их споры в высушенном состоянии сохраняют жизнеспособность в
течение нескольких месяцев. Передача происходит при контакте с инфицированным
человеком или животным либо через предметы обихода. В возникновении
патологических процессов на коже определённую роль играют изменения рН среды. В
современных природных условиях трихофития имеет ряд характерных особенностей -
изменился видовой состав возбудителей. Основным возбудителем является
фавиформный трихофитон, удельный вес которого составляет 80-85% [7].
Возбудитель данной болезни гриб, относящийся к
роду Trichophyton.
Мицелий гриба не отличается устойчивостью. Споры же весьма устойчивы: в
помещениях сохраняются 4-10 лет, на шерсти животных - 12-15 месяцев, в почве -
1,5 года, в навозе и навозной жиже - 8 месяцев, патологическом материале (кожа,
волосы) при высушивании - более двух лет. Клетки грибов состоят из оболочки
протоплазмы, ядра и ряда включений. Имеют в своем составе жир, витамины,
гликоген и кристаллы органических солей. В естественных условиях дерматофиты
образуют мицелий, распадающийся на артроспоры, а в культуре на питательных
средах - обычно обильный и разнообразный рост. Споры образуются внутри и вне
мицелия. Большинство грибов являются аэробами [19].. mentagrophytes - споры
мелкие - 3-5 мкм. Культуры растут быстро, колонии появляются на 3-5-й день,
зрелые на 14-16-й день. Колонии белые, кремовые, темно-желтые, могут быть порошистые.
Бархатистые. Встречаются спиральные окончания спор. Микроконидии
многочисленные, округлые или овальные. Артроспоры отсутствуют. Микроконидии
булавовидной формы (рис.1) [21].
Рис.
1. Trichophyton mentagrophytes var. gypseum
. verrucosum - крупноспоровые грибы от 5-ти до
8-ми мкм, поражают волос по типу эктотрикс (рис. 2). Их элементы в большинстве
случаев располагаются вне волоса, споровой чехол находится у основания волоса и
хорошо выражен. Грибы растут медленно на сусло-агаре или агаре Сабуро. Зрелые
колонии появляются на 15-25 день. Колонии белые, серые, кожистые, возвышенные
или плоские, складчатые или бугристые, растущий край ровный, лучистый,
паутинистый. Мицелий ветвящийся, микроконидии (алейрии) овальные, грушевидные,
артроспоры округлой формы. Хламидоспоры терминальные или интеркалярные.
Микроконидии удлинённые [34].

Рис. 2. Trichophyton
verrucosum
Поражения чаще всего
обнаруживаются на коже головы (возле носа, глаз), конечностей, шеи; могут быть
и на других местах. На пораженных участках вначале наблюдается шелушение кожи и
обламывание волос, вследствие чего образуются плешины. Затем на них появляются
маленькие, быстро засыхающие пузырьки, покрывающиеся серовато-белыми сухими
корками. Участки поражения постепенно увеличиваются, расширяясь к периферии. У
больных животных понижается прирост массы тела, снижается качество шерсти и
уровень естественной резистентности [10].
Носителями патогенных дерматомицетов являются
мыши, крысы и другие грызуны. У собак и кошек стригущий лишай возникает и легко
распространяется при нарушении зоогигиенических правил содержания, поэтому
особенно часто он встречается у бездомных, бродячих животных. Такие животные
представляют наибольшую опасность и для человека (прежде всего для детей).
Неблагоприятные погодные условия и поверхностные повреждения кожи способствуют
проявлению стригущего лишая [25].
Наиболее часто микроспория и трихофития поражают
молодых животных - щенков и котят в возрасте до 1 года. Распространению
заболеваний способствует нарушение зоогигиенических и ветеринарно-санитарных
правил содержания, кормления и эксплуатации животных (нарушение нормального
микроклимата, скученное содержание, перемещения и перегруппировки животных, а
также массовая контактная экспертиза во время выставочных мероприятий) [27].
В последние 30-40 лет
зооантропонозную трихофитию с атипичной формой локализации патологического
процесса не регистрировали. Преимущественным (97,9%) возбудителем заболевания
является Trichophyton
verrucosum. В 2011 году на
территории Российской Федерации было зарегистрировано 2,3 случая трихофитии на
100000 собак. Наиболее часто трихофития встречается в Южном федеральном округе
(показатель заболеваемости составил 5,7 и 6,7 на 100000 собак в 2010 и 2011 гг.
соответственно). К регионам с высокой заболеваемостью трихофитией у собак
относятся республики Башкортостан, Дагестан, Кабардино-Балкария, Ингушетия,
Саха (Якутия). На территории Северо-Западного территориального округа Российской
Федерации (РФ) трихофития у собак регистрируется спорадически, хотя в последние
годы отмечается тенденция к постепенному росту заболеваемости. Этому
способствуют активная миграция населения из южных регионов России и Средней
Азии, ослабление ветеринарного контроля, слабый уровень знаний о клинической
картине трихофитии специалистов-дерматологов и врачей других специальностей
[19].
1.2 Патогенез.
Клинические признаки трихофитии у собак
Возбудители трихофитии - антропофильные грибы,
поражающие гладкую кожу, волосы и ногти. При обитании на коже воспалительные
явления неглубокие, нерезко выраженные. Грибы располагаются в сердцевине
волоса. Инфильтративно-нагноительная трихофития вызывается грибами,
паразитирующими на человеке и животных, т.е. относящимися к группе
зооантропофильных. По характеру и свойствам культур на питательных средах они
классифицируются как Tr. mentagraphytes (var. gipseum), Tr. verrucosum (var.
faviforme). Располагаясь по наружной поверхности волоса и образуя как бы чехол
вокруг него. В зависимости от величины спор и их биологических особенностей
выделяют мелкоспоровую разновидность, паразитирующую у мелких домашних
животных, мышей, крыс, кроликов, морских свинок. Крупноспоровая разновидность
обитает у крупных домашних животных - собак, лошадей, коров, телят, овец [39].
Трихофитоны размножаются в тканях, содержащих
роговое вещество - керотин, который имеется в роговом слое эпидермиса кожи и в
волосе. Возбудитель выделяет токсины и кератолитические ферменты, вызывающие
поверхностное воспаление и разрыхление рогового слоя кожи. При условиях,
благоприятных для развития, возбудитель проникает к устью волосяных фолликулов
и в шейку волоса, разрушает кутикулу, внутреннее волосяное влагалище, корковое
вещество, что ведет к нарушению питания волоса и его выпадению. В месте
поражения развивается гиперкератоз [2].
Клинические признаки. Инкубационный
период длится от недели до месяца. Заболевание протекает хронически и
выражается в появлении на коже небольших безволосых пятен округлой формы, покрытых
чешуйками и корочками асбестово-серого цвета (рис. 3). Чаще всего поражается
кожа головы, шеи, конечностей. В запущенных случаях множественные пятна могут
сливаться и захватывать значительные участки тела. Зуд отсутствует или слабо
выражен [14].

Рис. 3.
Трихофития у щенка
При глубокой форме трихофитии у собак происходит
нагноение волосяных мешочков, под корками скапливается много гноя. Стригущий
лишай может поражать и когти (онихомикоз). В этом случае они становятся
толстыми и деформируются. В легких случаях заболевание протекает без зуда. На
пораженных местах могут появиться корочки и струпья, которые позже начинают
мокнуть. Собака лижет их и пытается чесать. Иногда отмечается обширное
поражение кожи. В легких случаях заболевание приводит к выпадению волос и
локальному шелушению кожи [18].
ГЛАВА 2. ДИАГНОСТИКА. ЛЕЧЕНИЕ.
ПРОФИЛАКТИКА И МЕРЫ БОРЬБЫ ТРИХОФИТИИ У СОБАК
В последние годы отмечается
клиническое многообразие трихофитии у собак, наличие атипичных и стертых
клинических форм, что, в свою очередь, затрудняет своевременную диагностику.
Атипичные формы заболевания необходимо дифференцировать с простым лишаем у
собак, розовым лишаем Жибера, псориазом, микробной и себорейной экземой,
атопическим дерматитом, гидраденитом, хронической пиодермией, вульгарным
сикозом [20].
Поверхностная, инфильтративная
и нагноительная формы трихофитии представляют собой последовательные стадии
развития патологического процесса. Клиническая картина поверхностной трихофитии
достаточно характерна. У собак появляются один или несколько очагов розового
цвета, округло-овальной формы, с четкими границами, шелушением; по периферии
очагов могут располагаться фолликулярные узелки. При инфильтративной форме
очаги поражения резко очерчены, кожа гиперемирована, отечна, инфильтрирована и
несколько возвышается над общим уровнем, могут встречаться единичные пустулы,
корочки гнойно-геморрагического характера.
При развитии процесса на коже
часто поражаются пушковые волосы, что приводит к развитию остиофолликулитов;
при поражении головы или области бороды и усов волосы обламываются.
Нагноительная форма трихофитии у собак чаще развивается на волосистой части
головы либо в зоне роста бороды и усов вследствие дальнейшего прогрессирования
микотического процесса.
Гиперемия кожи в области очага
поражения усиливается, появляются множественные фолликулиты, сливающиеся в
массивный инфильтрат, значительно выступающий над поверхностью кожи и
болезненный при пальпации. Как правило, при нагноительной форме трихофитии
наблюдается увеличение регионарных лимфатических узлов, повышение температуры
тела, нарушение общего состояния животного. При инфильтративно-нагноительной
форме трихофитии волосы в очагах поражения очень легко эпилируются. Зачастую
при развитии рубцовых изменений кожи волосы полностью не восстанавливаются
[14].
Клинический диагноз трихофитии у собак должен
быть подтвержден данными лабораторных исследований. В обычной клинической
практике при трихофитии ограничиваются микроскопическим и культуральным методами
исследования зараженного материала. Перед микроскопией пораженные объекты
(кожные чешуйки, волосы, покрышки пузырьков) предварительно обрабатывают
10%-ным раствором едкого калия или 25%-м раствором натрия гидроксида для
просветления препарата. Поэтому часто этот метод диагностики называют
КОН-тестом. Микроскопическая идентификация микромицетов напрямую в клиническом
образце является быстрым диагностическим методом, однако наличие
ложноотрицательных результатов более чем в 15% случаев указывает на недостаточную
специфичность и чувствительность метода. Данным методом можно выявить наличие
дерматомицетов, но идентификация их не представляется возможной. Также этот
тест ограничивает субъективная оценка врача-лаборанта. Так, чувствительность
прямой микроскопии при грибковом поражении головы животного, по данным ряда
авторов, варьирует от 67 до 91% [31].
С целью повышения специфичности
и чувствительности разработан ряд методик, позволяющих просто и быстро
идентифицировать различные виды микромицетов. В микологических лабораториях
просветление препаратов для микроскопического исследования проводят 15-30%-ным
раствором КОН, в который добавляют 5-10%-ный раствор темно-синих чернил фирмы
«Паркер» (Parkers
Superchrome
Blue-Black
Ink). При этом методе
гифы и споры дерматомицетов окрашиваются в голубой цвет [25].
В последнее время разработан и
внедрен в практику новый метод микроскопии нативных препаратов с окраской
калькофлюором белым. Этот реагент в качестве отбеливающего средства
используется в текстильной и бумажной промышленности. Совместное применение
калькофлюора белого с КОН позволяет выявлять как молодые, так и зрелые гифы
дерматомицетов. Применение метода окраски калькофлюором белым при
микроскопической диагностике дерматомикозов позволяет на 10% увеличить выявляемость
грибковой инфекции по сравнению со стандартным КОН-методом. Краска
флуоресцирует в ультрафиолетовом свете (при коротковолновом облучении).
Визуализация проводится под флуоресцентным микроскопом [40].
Для окрашивания гистологических срезов волос широко
применяют метод PAS
(периодическая кислотная реакция) окрашивания. Последний мало отличается от
процедуры окрашивания тканевых срезов и сопровождается окраской определенных
гликанов (полисахаридов), находящихся в клеточной стенке дерматомицетов. С целью
выявления наиболее информативного метода диагностики J.
Weinberg и соавт. сравнили
четыре диагностических теста, а именно: микроскопический, культуральный, метод
люминесцентной микроскопии с белым калькофлюором и биопсии ногтя. Авторы
установили чувствительность микроскопии в 80%, культурального метода в 59% и
биопсии ногтя - в 92% по сравнению с люминесцентной микроскопией с белым
калькофлюором, который был выбран в качестве основного метода. Преимуществом
всех вышеперечисленных методик микроскопии является их быстрая и простая
техника проведения, однако они не дают возможность идентифицировать вид
микромицетов [12].
Для установления видовой
принадлежности возбудителя проводится посев материала на питательную среду
Сабуро с последующей идентификацией выделенной культуры. Известен способ
выделения дерматомицетов на плотной среде Сабуро с селективными добавками в
виде пенициллина (20000 ЕД) или стрептомицина (40000 ЕД), гентамицина (0,005
г/л), левомицетина (0,16 г/л). Недостатком данной культуральной среды является
медленный рост выделяемых культур, что обуславливает длительные сроки
диагностики. С целью сокращения сроков роста культур рядом авторов предложены
различные модификации состава среды Сабуро. Описан способ культивирования
дерматофитов в жидкой среде, содержащей кератин [28].
З.Р. Хисматуллиной и соавт. был
разработан способ идентификации дерматомицетов с использованием культуральной
среды Сабуро с гидролизатом кератина, позволяющий сократить сроки выделения
грибов из материала больного животного. Увеличение скорости роста культур
микромицетов происходит при содержании в питательной среде гидролизата кератина
выше 20 г/л. Высев дерматофитов предлагаемым способом позволяет проводить
идентификацию для Tr.
mentagrophytes
var. gypseum
на 4-5-й день, для Tr.
verrucosum - на 7-8-й день
[33].
Одной из попыток
усовершенствовать и обеспечить массовую культуральную диагностику
дерматомицетов является разработка тестовой среды для дерматофитов (DTM,
delmatophyte
test medium),
содержащей агар Сабуро с антибиотиками, циклогексимидом и индикатором роста
культуры дерматофитов. Внедрение среды DTM
произвело на свет концепцию «офисного культивирования», при котором появилась
возможность наблюдать рост в одноразовых чашках не в специальной лаборатории, а
непосредственно в кабинете врача-ветеринара, поскольку рост культуры идет при
комнатной температуре [34].
Даже при соблюдении всех правил
сбора материала, при наличии оборудования и высоком профессионализме
сотрудников лаборатории число выявляемых положительных результатов
культурального исследования весьма невелико. Культуральный метод - это
специфический диагностический тест, который требует до 8 недель времени, прежде
чем результат будет получен. Однако при этом, по данным зарубежной литературы,
доля положительного культурального исследования едва достигает 50%, в
отечественных исследованиях возбудитель не удается выделить и в 64% случаев.
Это обусловлено техническими погрешностями (нарушение правил забора материала,
его транспортировки и т.д.), но чаще всего - проведением предшествующей (как
правило, местной) антифунгальной терапии у собак их владельцами. Владельцы
собак часто занимаются их самолечением с применением наружных антимикотических
средств, что приводит не только к изменению клинической картины, но и, естественно,
к появлению ложноотрицательных результатов исследования при дерматофитиях [30].
Некоторыми авторами
неоднократно предлагались разные диагностические подходы, которые позволили бы
усовершенствовать идентификацию грибковой инфекции, дополнить или заменить
классические методы. Поэтому, помимо рутинных микроскопического и
культурального методов, активно изучаются новые возможности, такие как
определение антигена Tr.
verrucosum
var. verrucosum
методом иммуноферментного анализа, а также прямая ДНК-диагностика
дерматомицетов. Молекулярно-биологические методики, такие как РСИ-RFLP,
ПЦР реального времени и мультиплексный ПЦР, были адаптированы для определения
дерматомицетов в клинических образцах. Эти молекулярные методы имеют хороший
потенциал для прямого определения дерматомицетов, вместе с тем они еще
нуждаются в стандартизации для обычных клинических лабораторий [1].
В 2004 году в России были
разработаны и успешно применены в клинических условиях первые генетические
зонды для прямой диагностики дерматофитии кожи, волос и ногтей. Данный проект
был инициирован в 2003 году Национальной академией микологии с целью изучения
возможности применения полимеразной цепной реакции (ПЦР) в выявлении Trichophyton
rubrum в клинических
образцах. Затем был создан аналогичный метод для Trichophyton
mentagrophytes [15].
Лишь несколько авторов
сравнивали в клинических образцах КОН-микроскопию и культивирование с
ПЦР-методом. В исследовании Nagao
и соавт. определили Trichophyton
rubrum посредством
«вложенной» ПЦР, имеющей мишенью ген внутреннего транскрибируемого спейсера 1
(ВТС1), который был негативен как по данным КОН-микроскопии, так и по данным
культивирования. Yan
и соавт. сравнили случайно праймируемую ПЦР с общепринятыми методами показали,
что случайно праймируемая ПЦР - это более быстрый, чувствительный и специфичный
метод для диагностики дерматофитий. Подобных исследований в отношении
возбудителей трихофитии у собак не проводилось [28].
В соответствии с общими
тенденциями, наблюдаемыми в сфере диагностики, ПЦР реального времени может в
будущем стать заменой методам прямой микроскопии и культивирования. Высокая
цена ПЦР на сегодняшний день и редкость применения этого метода в ветеринарных
клиниках является лимитирующим фактором, но это может измениться в результате
уменьшения цен на рынке реагентов и появлением сбережений, вызванных заменой
общепринятой диагностики [6].
Таким образом, традиционные доступные методы
лабораторной диагностики трихофитии у собак не всегда позволяют определить вид
возбудителя и соответственно выбрать оптимальный метод лечения. Назревшая
необходимость в методах быстрой и точной идентификации возбудителей открывает
перспективы для внедрения в диагностику данного заболевания такого
современного, высокочувствительного и специфичного метода исследования, как
метод полимеразной цепной реакции [13].
После подтверждения диагноза
трихофитии у собак с лечебной целью вводят 2- или 3-кратно вакцину против
трихофитии. Одновременно назначают средства, обладающие фунгистатическими и
фунгицидными свойствами. В начальном периоде болезни пораженные места
обрабатывают раствором салициловой кислоты на 5%-й настойке йода, а также
жидкостями и пастами, обладающими фунгицидными свойствами. Достаточно широко
представлен ряд готовых фунгицидных форм: фунгин, нитрофунгин; мази:
ундециновая, цинкундан, микосептин, «Ям», клотримазол, вединол, экалин,
травоген; раствор «Никлофен», эпацид F,
Апит. Смазывать или втирать в пораженные участки кожи 2-3 раза в день. Лечебный
эффект усиливается при одновременном введении гризеофульвина или низорала.
После выздоровления для ускорения роста волос в пораженные участки кожи втирают
Carbolici
cristall, Ricini
и др. Ежедневно втирают в кожу больного животного для стимуляции роста волос
[24].
Профилактика трихофитии у животных
создает предпосылки для ликвидации трихофитии у человека
<#"819476.files/image004.gif">
Рис. 4. График температуры, пульса и
частоты дыхания щенка с трихофитией в дни протекания болезни.
Эпикриз
Трихофития - распространенное
среди дерматомикозов собак заболевание, основными возбудителями которой
являются Trichophyton
verrucosum и Trichophyton
mentagrophytes
var. gypseum.
Трихофития у собак встречается чаще чем другие дермофитии. Болеют обычно щенки,
плохо питающиеся собаки, а также животные с пониженным за счет другого
заболевания иммунитетом. Источником возбудителя являются больные и переболевшие
животные. Это кожное заболевание передается собакам от других животных через
поврежденные участки кожи, путем контакта со спорами, находящимися в земле, на
игрушках и мебели.
Больная собака, французский бульдог, сука,
15.04.2012 г.р. находится на лечении с 08.07. по 18.07. 2012 года с диагнозом:
нагноительная трихофития подбородка (1 очаг). При поступлении владелица собаки
предъявила жалобы на появление у щенка слегка заметной сыпи на подбородке,
затем произошло увеличение площади поражения, на коже образовалась красноватая
корка, а также началось выпадение волос в месте поражения. 6 июля у щенка на
пораженном месте образовалась лысина с четкими границами. Из-под корки начал
течь гной.
Проведено обследование: физикальное, анализ на
грибы, ОАК, ОАМ, БХ крови.
Проведено лечение: введена вакцина против
трихофитии. Пораженные места в течение 10 дней обрабатывались раствором
салициловой кислоты на 5%-й настойке йода, а также фунгином и жидкостью
Кастеллани 2 раза в день. Одновременно вводился гризеофульвин внутрь по 1 таб.
2 раза в день. После выздоровления для ускорения роста волос в пораженные
участки кожи рекомендовано втирание Carbolici
cristall или Ricini
ежедневно.
ЗАКЛЮЧЕНИЕ
Трихофития - (Trichophytosis),
трихофитоз, стригущий лишай, инфекционная болезнь животных и человека,
вызываемая несовершенными грибами рода Trichophyton, характеризующаяся у
животных появлением на коже участков с обломанными волосами, покрытых корками и
чешуйками. Распространена в большинстве стран мира, в том числе и в России. Т.
verrucosum вызывает главным образом трихофитию крупного рогатого скота, зебу,
буйволов, верблюдов, реже серебристо-чёрных лисиц, песцов. T. mentagrophytes
(gypseum) - основной возбудитель трихофитии собак, кроликов, серебристо-чёрных
лисиц, песцов, мышей-полёвок, сусликов, а также зверей, содержащихся в
зоопарках, питомниках и др. [17].
Трихофитией болеют животные
всех видов и возрастов. Источники инфекции - больные и переболевшие животные.
Факторы передачи - инфицированные помещения, инвентарь. Мышевидные грызуны -
постоянный резервуар T. mentagrophytes в природе.
Инфицированные возбудителями
трихофитии сено, солома, пух, волос, шерсть служат источником заражения
кроликов, пушных зверей, крупного рогатого скота, овец, лошадей. Микротравмы
способствуют внедрению возбудителя. В зверохозяйствах, кролиководческих
комплексах, откормочных совхозах, питомниках, где концентрируется большое
поголовье животных, трихофития может протекать как энзоотия [21].
Переболевшие трихофитией
животные приобретают длительный напряжённый иммунитет. Показатели
серологических реакций (РА, РСК) сохраняются лишь 2-3 месяца, через 6-8 месяцев
они могут полностью угаснуть. При поверхностной трихофитии заражение людей
(особенно часто детей) происходит при контакте с больным животным и через
инфицированные предметы. На коже появляются округлые розовые пятна с чёткими
приподнятыми краями и шелушением в центре. В очагах на волосистой части головы
волосы разрежены и обломаны. Поражённые ногти - грязно-серые, тусклые,
неровные, края их утолщены, крошатся. Глубокая трихофития возникает при
заражении грибами, паразитирующими у животных (особенно опасны больные
трихофитией пушные звери, собаки, кролики и кошки). Отмечают воспалительные
нагноившиеся узлы с корками на поверхности, облысение [35].
СПИСОК ЛИТЕРАТУРЫ
1. Авилов
В.М. Ветеринария. - СПб.: Питер, 2006. - 338 с.
2. Азаров
В.Н. Основы микробиологии и санитарии. - М.: Экономика, 1996. - 205 с.
3. Антонов В.Б., Медведева Т.В., Леина Л.М. и
др. К вопросу об инфильтративно-нагноительной трихофитии // Успехи медицинской
микологии. Т. 8. - М.: Национальная академия микологии, 2006. - С. 185 -187.
4. Астраханцев
В.И. Болезни собак. - М.: Колос, 2001. - 258 с.
5. Белов
Е.П. Болезни собак. - М.: Агропромиздат, 1990. - 368 с.
. Борисов
Л.Б. Медицинская микробиология, вирусология, иммунология.- М.: Медицинское
информагенство, 2005.- 735 с.
. Воробьев
А.А. Медицинская и санитарная микробиология.- М.: Академия, 2003.- 462 с.
. Ветеринарная
лабораторная медицина. Интерпретация и диагностика: [собаки, кошки, лошади,
жвачные животные, свиньи]. Мейер Д., Харви Дж. - М.: Софион, 2007.- 458 с.
. Глотова
Т.И. Дерматомикозы собак и кошек в условиях города // Ветеринария, 1998, №1. С.
59-61.
. Гинзбург
А.Г. Организация и планирование ветеринарного дела. - М.: Аспект-Пресс, 2005. -
492 с.
. Гусев
М.В. Микробиология. - М.: Академия, 2009. - 464 с.
12. Евсеенко К.А. Новые горизонты медицинской
микологии// Мед. новости. - 2003. - Т. 12. - С. 4-9.
13. Кашкин П.H,
Лисин В.В. Практическое руководство по медицинской микологии. - Л.: Медицина,
1990. -195 с.
14. Kyxap
E.В. Поиск антигенов
для ИФА-диагностики зооантропонозной трихофитии // Проблемы мед. микол. - 2007.
- Т. 2. - С. 73-74.
. Лещенко П.Н. Лабораторная диагностика
грибковых заболеваний. - М.: Медицина, 1987. - 146 с.
16. Литвинов
A.M. Дерматофитозы кошек и собак (профилактика и лечение)//Ветеринария. №11,
2000. С.51-53.
17. Луферов
А.Ф. Методические рекомендации по оздоровлению домашних очагов зооантропонозной
микроспории и трихофитии. - Минск: Высшая школа. 1998. - 15 с.
. Лысак
В.В. Микробиология. - Минск: БГУ, 2007. - 426 с.
19. Медведева Г.В., Антонов В.Б., Леина Л. М. и
др. Трихофития: современные представления об этиологии, клинической картине,
особенностях диагностики и терапии // Клин. дерматол. и венерол. - 2007. - Т.
4. - С. 70-74.
20. Медведев
К.С. Болезни кожи собак и кошек / К.С. Медведев. Киев: ВИМА, 1999.-218 с.
21. Медицинская
микробиология. / Под ред. А.М. Королюка, С.Б. Стойчакова. - СПб.: ЭЛБИ, 2002.-
267 с.
. Микробиология
и иммунология. / Под ред. А.А. Воробьева.- М.: Медицина, 2005.- 492 с.
. Минеева
Л.А. Микробиология. - М.: Академия, 2010. - 464 с.
24. Нуралиев М.Д. Эпидемиология, особенности
клиники и совершенствование терапии трихофитии в условиях жаркого климата. -
Душанбе, 2007.- 200 с.
25. Организация
и экономика ветеринарного дела / Под ред. А.Д. Третьякова. - М.: Проспект,
2001. - 260 с.
26. Основы
микробиологии, вирусологии и иммунологии. / Под ред. Ю.С. Кривошеина.- М.:
Высшая школа, 2001.- 224 с.
. Петрович
С.В. Микозы животных. М.: Росагропромиздат. - 1989. - 173 с.
. Райкис
Б. Общая микробиология с вирусологией и иммунологией. - М.: Триада - Х, 2002.-
347 с.
. Саркисов
А.Х. Диагностика грибных болезней животных/А.Х. Саркисов, В.П. Королева, Е.С.
Квашнина, В.Ф. Грезин // М.: Колос. - 1971. - 144 с.
. Справочник
ветеринарного врача / Под ред. Н.М. Алтухова. - М.: Колос, 1996. - 352 с.
31. Степанова Ж.В., Гребенюк В.Н., Воробьева
И.А. и др. Диагностические ошибки при зооантропонозной трихофитии // Вестн.
дерматол. - 2001. - Т. 6. - С. 36-38.
32. Федюк
В.И. Справочник болезней собак и кошек.- М: Академия. - 2001. - 338 с.
33. Хисматуллина 3.Р. Мухамадеева О.Р. Способ
выделения дерматофитов // Вестн. дерматол. - 2006. - Т. 2. - С. 25-27.
34. Хисматуллина З.Р., Фахретдинова X.С,
Мухамадеева О.Р. Зооантропонозная трихофития. - Уфа: Башкириздат, 2004. - 125
с.
35. Arabatzis
М, Bruijnesteijn
van Coppenraet
L.E.
S., Kuijper
E.J.
et al.
Diagnosis of common dermatophyte infections by a
novel multiplex real-time polymerase chain reaction detection/identification
scheme // Br. J. Dermatol. - 2007. - Vol. 157.-P. 681-689.
. Jennings M.B., Rinaldi M.G.
Confirmation of dermatophytes in nail specimens using in-office dermatophyte
test medium cultures. Insights from a multispecialty survey // J.Am. Podiatr.
Med. Assoc. - 2003. - Vol. 93, №3. - P. 195-202.
. Rippon J.W. Medical
mycology // The Pathogenic Fungi and the Pathogenic Actinomycetes 3rd ed. -
Philadelphia: WB Saunders, 1988.
. Weinberg J.M., Koestenblatt
E.K., Tutrone W.D. etal Comparison of diagnostic methods in the evaluation of
onychomycosis // J. Am. Acad. Dermatol. - 2003. - Vol. 49, №2. - P. 193-197.
. Yang G., Zhang M., Li W. et
al Direct species identification of common pathogenic dermatophyte fungi in
clinical specimens by semi-nested PCR and restriction fragment length
polymorphism //Mycopathologia. - 2008. - Vol. 166, №4. - P. 203-208.
40. Yan
D. Detection of fungiinliquor workers with tinea corporis and tinea cruris
using arbitrarily primed polymerase chain reaction // Zhonghua Lao Dong Wei
Sheng Zhi Ye Bing Za Zhi. - 2007. - Vol. 25, №3. - P. 133-135.